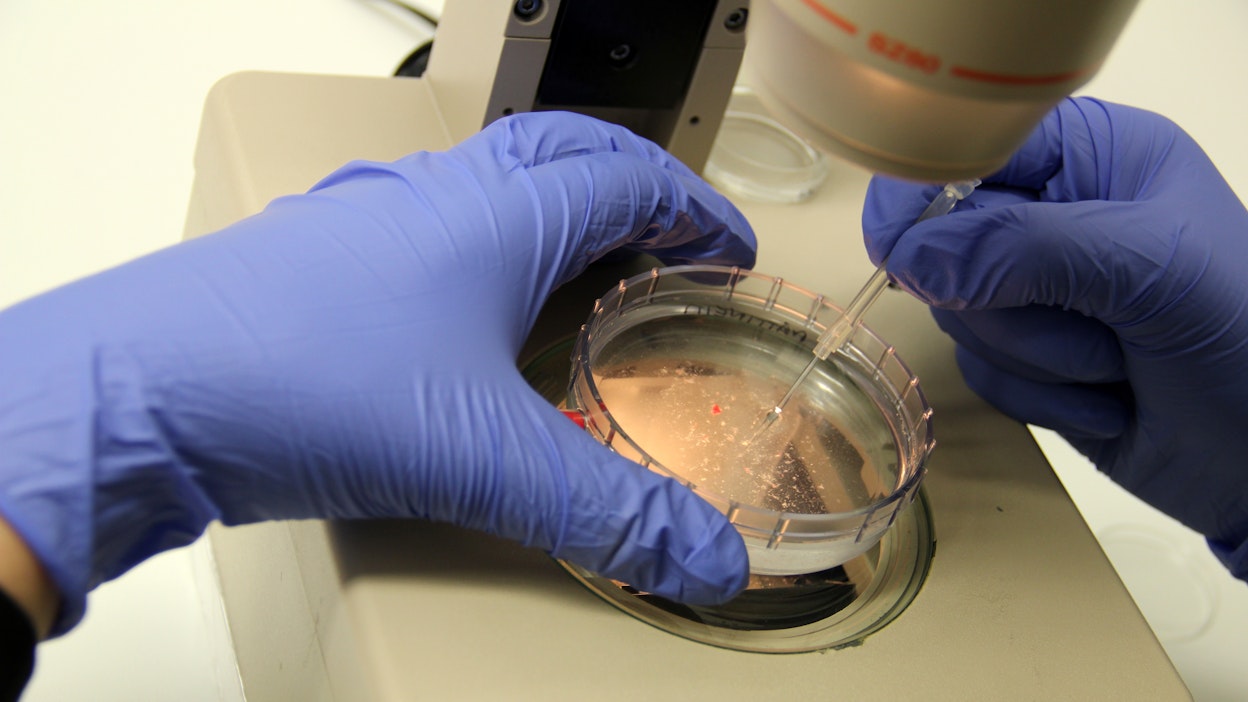
Sähköisen lähete ei syrjäytä pdf-pohjaista lähetettä, Ruokavirasto kertoo.

Ruokavirasto otti käyttöön sähköisen lähetteen eläintautitutkimuksiin
Henkilöasiakkaat kirjautuvat Ruokaviraston Touko-asiointipalveluun Suomi.fi.tunnuksilla. Yritysasiakkaalla on oltava Suomi.fi-valtuutus.Ruokaviraston Eläinterveystutkimuksen laboratoriopalveluissa on otettu käyttöön sähköinen lähete 3.6. alkaen. Lähete toimii Ruokaviraston Touko-asiointipalvelussa.
Henkilöasiakkaat kirjautuvat palveluun Suomi.fi-tunnistautumisen kautta. Yritysasiakkaat voivat kirjautua palveluun Suomi.fi-valtuutuksen jälkeen. Jos henkilöllä on yrityksensä asiointi- ja nimenkirjoitusoikeus kaupparekisterissä tai YTJ:ssä, hän voi asioida suoraan Touko-asiointipalvelussa yrityksen nimissä ilman erillisiä valtuutuksia. Henkilöasiakkaat voivat myös valtuuttaa toisen henkilön asioimaan puolestaan.
Sähköinen lähete täytetään Touko-asiointipalvelussa ja lähetteellä pyydetään valitsemaan tilattavat tutkimukset sekä esimerkiksi täyttämään tilaajan ja näytteen tiedot. Lopuksi lähetteelle muodostuu seurantakoodi, joka liitetään näytelähetyksen mukaan.
Tutkimusvastaus voidaan toimittaa Touko-asiointipalveluun tai tilaajalle sähköpostilla tai kirjepostina. Touko-asiointipalvelussa näkyvät myös kaikki aikaisemmat tutkimukset, jotka on tilattu käyttämällä sähköistä lähetettä.
Ruokaviraston pdf-pohjaiset tutkimuslähetteet ovat edelleen käytettävissä. Provet-eläinlääkäriohjelmiston kautta toiminut tutkimuslähete poistuu käytöstä 30.6. vähäisen kysynnän vuoksi. Ruokavirasto kertoo.
Ohjeita sähköisen lähetteen käytöstä on Ruokaviraston verkkosivuilla.
Artikkelin aiheet- Osaston luetuimmat